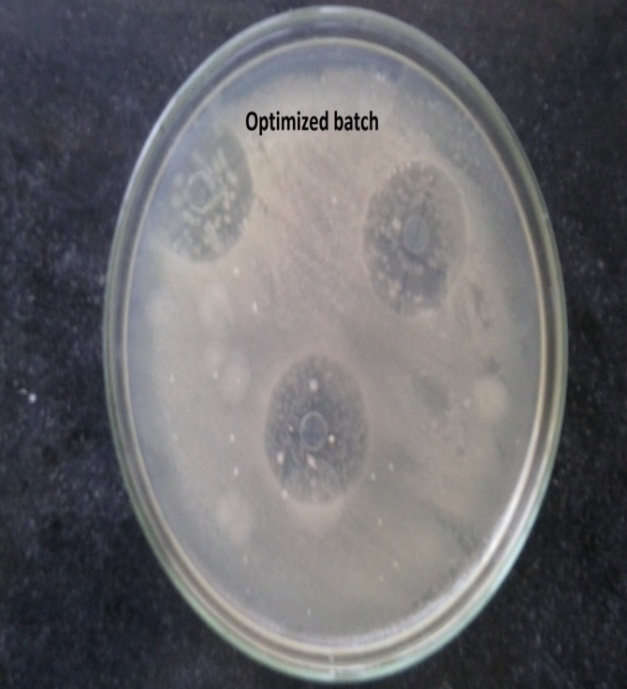

Int J Curr Pharm Res, Vol 9, Issue 5, 100-106Original Article
EFFECTIVE MANAGEMENT OF ODONTOGENIC INFECTIONS THROUGH CONTROLLED FASHION BY POLYMERIC DEVICE CONTAINING MOXYFLOXACIN
GORLE A. P., MAHALE H. V., PATIL C. S.
Department of Pharmaceutics, R C Patel Institute of Pharmaceutical Education and Research Shirpur, Dhule, Maharashtra 425405, India
Email: ashishgorle@rediffmail.com
Received: 24 May 2017, Revised and Accepted: 22 Jul 2017
ABSTRACT
Objective: Present work demonstrates the use of film that releases the drug at a pre-programmed manner. Several methods have been explored for management of moxifloxacin in dealing of Odontogenic infections which are mainly caused by necrotic pulp or by bacterial invasion from the periodontal tissue. These are usually mixed bacterial infections, and they penetrate mostly into the soft and bony oromaxillofacial tissues to produce submucosal infiltrates and abscesses.
Methods: The films were developed with the intention to minimize the dose of a drug, to deliver definite concentration and to preserve dosage at its site for a longer period by this means gets a better patient compliance. Moxifloxacin films were prepared by solvent casting technique using gellan gum at different concentrations and PEG 400 as plasticizers. Compatibility study such as FT-IR and DSC also performed to check the interaction between drug and excipients used. The formulations were evaluated for their thickness, weight uniformity, folding endurance, content uniformity, surface pH, In vitro drug release. Optimized formulations were subjected to in vitro antibacterial activity and stability studies to assess the effectiveness of the formulations.
Results: Formulations shown the good uniformity of drug content, there was no any kind of effect on moisture loss test. Weight and thickness of the films were found to be uniform. Plasticizer like PEG400 was found to influence their effect on drug release as well as characteristics of films.
Conclusion: In vitro studies revealed that the formulations provide the best alternative to prolong drug release at the end of 10 h and formulations remained stable with intact at ambient conditions.
Keywords: Moxifloxacin Hydrochloride, Dental film, Physical characterization, In vitro release, Antibacterial study
© 2017 The Authors. Published Published Innovare Academic Sciences Pvt Ltd. This is an open access article under the CC BY license (http://creativecommons.org/licenses/by/4.0/)
DOI: http://dx.doi.org/10.22159/ijcpr.2017v9i5.22149
INTRODUCTION
Oral cavity makes available varied surroundings for colonization of a broad range of microorganisms. Substantial efforts are exhausted on the prevention and management of infections. Health of public campaigns globally has made considerable attention in the enhancement of hygiene practices and anticipation of diseases. The fundamentals for any infection include a susceptible host, virulent organism (s) and the favourable conditions. This is frequently given as the changed balance among disease and health or Odontogenic infections are invariably caused by bacteria. Dental infections such as gingivitis, periodontitis, dental caries and odontogenic infections etc are consequences in frequent dental visits. They can range in severity from a gentle buccal mucosal space infection to a severe life-threatening multi-space infection. All dentists should be accompanying with the prompt diagnosis and management of these kinds of infections. This study represents the organization of odontogenic infections including appropriate antibiotic selection and the suggestions for a referral to a specialist. The oral route is considered as the most promising way for the administration of many pharmaceuticals. The factors such as gastric emptying process, the gastrointestinal transit time of dosage form, drug release from the dosage form and site of absorption of drugs are the most prominent factors which determine the effectiveness of the oral drug delivery systems [1].
Despite the predominance of one or two species, odontogenic infections are caused by a complex interplay of microflora that may normally inhabit the oral cavity. Typically, this means that the infection may be initiated by the aerobic bacteria gaining entry into the body through a break in the natural barriers of the body (skin, mucosa, tears, saliva, and enamel). This causes inflammation, which reduces the oxygen content of the environment, thus making it more anaerobic. This environment becomes more conducive to support anaerobic organisms. It is this synergy that causes serious infections. Significant efforts are directed at reducing the incidence and severity of periodontal infections, especially due to its established associates with a systemic health problem. The findings of penicillin and consequent advances in antimicrobial therapy have significantly improved outcomes of infection treatment. Despite this fact, oral infectious diseases remain among the top reasons for seeking healthcare in the world. Dentists, regardless of their focus of practice, remain the frontline practitioners for diagnosis and management of oral and facial infections [2].
Although the incidence of odontogenic infections has declined in recent years as a result of the improvement in oral health care, it is still the root-cause of infectious disease and the major ordinary source for consultation and intervention by dentists [3]. Odontogenic infections affect the entire population, from children to the elderly population. The most common source of infections are those arising from dental caries, dentoalveolar infections (infections of the pulp and periapical abscess), gingivitis, periodontitis (including peri-implantitis), aponeurotic space infections, osteitis and osteomyelitis [4, 5].
The treatment of odontogenic infections is based on two main elements: surgical treatment and antibiotic therapy. Management of patient with an odontogenic infection is a multifaceted approach involving (i) an examination and assessment of the patient, (ii) identifying the source of the infection, (iii) anatomic considerations, (iv) surgical intervention, (v) administration of the appropriate antimicrobial therapy, and (vi) referral to an appropriate provider if indicated [6]. Most odontogenic infections are mainly affected by more than one species of the bacteria normally observed within the oral cavity. Approximately 50% of odontogenic infections are caused by anaerobic bacteria alone, 44% by a combination of aerobic and anaerobic bacteria and only 6% by aerobic bacteria alone [7].
The aim of dental health care is to control the population of micro-organisms. Slowing or arresting of the oro-dental infections can be achieved by controlling bacterial plaque. Moxifloxacin is advanced new generation synthetic Fluoroquinolone derivative which is a broad-spectrum antibiotic with excellent bacterial coverage. High doses of antibiotics cause side effects such as gastrointestinal disorders, development of resistant bacteria and supra-infection. Systemic therapy has low benefit to high-risk ratio [8]. With advances in the understanding of the etiology and pathogenesis of periodontal disease, attention has been focused on local drug delivery systems. These include both sustained and controlled release polymeric dosage forms which after insertion into periodontal pocket, release antimicrobial agents above minimum inhibitory concentration for a sustained period of time. Thus intra-pocket devices have a high benefit to low-risk ratio [9].
The most important aspects of the study were to develop film loaded with Moxifloxacin Hydrochloride which delivers the drug sustainly to the dental cavity. By formulating films, we can directly place it to the targatted site and thus reduce the impact of antibacterial agent on other non-oral body parts hence reduces the systemic toxicity of the drug and better patient compliance.
MATERIALS AND METHODS
Materials
Moxifloxacin hydrochloride (drug) was obtained as a gift sample from Cipla Ltd. Mumbai (India). Gellan gum (Kelcogel®) was from Sigma-aldrich, Pvt. Ltd. (Germany), and purchased from Sudarshan Scientific labortories, Nashik (MS) and Dialysis Membrane MWCO 12000 Da. Purchased from Hi Media (Mumbai, India) Deionised water was used as the aqueous component. Other all the chemicals used were of analytical grade.
Microbiological material
A bacterial and fungal strain was procured from Microbial test culture collection (MTCC) Escherichia coli (MTCC 614), and Staphylococcus aureus (MTCC 1430). Nutrient agar and Potato dextrose agar was purchased from Hi Media Mumbai.
Method
Preformulation studies
Preformulation studies were carried out in order to find out the drug excipients compatibility. The samples of drug and excipients were intimately mixed, in equal parts and screened by FTIR and DSC after storage under accelerated conditions of temperature and humidity.
Infrared spectroscopy (FTIR)
FTIR spectra of pure drug Moxifloxacin HCL and the mixture of polymers were taken to study the interaction between them. A mixture of with Gellan Gum and Ethylcellulose N-20 were mixed separately with IR grade KBr in the ratio of 1:100 and compressed using motorized pellet press at 15 tones pressure [10].
Differential scanning calorimetry (DSC)
Firstly, the melting point of the drug was determined by capillary method then confirmed by DSC. Thermogram of Moxifloxacin HCL was obtained using DSC. Drug-excipients compatibility study was performed by Differential Scanning calorimetry (DSC) [10].
Film preparation
The formulations of Moxifloxacin hydrochloride were developed by using the polymer such as Gellan gum along with the use of plasticizer (PEG-400) by solvent casting method. The drug was dissolved in a10 ml distilled which is previously dissolved by putting the solution on a magnetic stirrer (rpm 30/min). In another side, gellan gum was dissolved in a 10 ml distilled water by warming. Then both the mixture was unformly mixed and plasticizer PEG-400 was slowly added ot it, then stirred well on a magnetic stirrer (rpm 30/min). The solution was then casted on a petridish (diameter 8.8 cm) mercury as a substrate. The solvent was allowed to evaporate slowly by inverting a glass funnel with a cotton plug closed into the stem of the funnel at room temperature for 24 h. After complete evaporation of the solvent, cast films were obtained, which were then cut into pieces, wrapped in an aluminium foil and stored in a desicator at room temperature in a dark place for further evaluation studies [11].
Table 1: Composition of formulation
| Ingredients | F1 | F2 | F3 | F4 | F5 | F6 |
| Drug (%) | 0.4 | 0.4 | 0.4 | 0.4 | 0.4 | 0.4 |
| Gellan Gum (%) | 3 | 2 | 4 | 2 | 2 | 2 |
| EC (%) | ---- | 1 | ---- | 2 | 2 | 1.5 |
| PVP | 2 | 2 | ---- | ---- | 1 | 1.5 |
| PEG-400 (% w/w of polymers) | 20 | 20 | 20 | 20 | 20 | 20 |
| DW (upto%) | 100 | 100 | 100 | 100 | 100 | 100 |
*EC: ethyl cellulose; PEG: Polyethylene glycol
Evaluation of formulations
Physical appearance and surface texture
This parameter was checked by doing a visual inspection of films and texture of films is evaluated.
Thickness uniformity
The thickness of the film was measured by using micrometre at three different points (Mitutoyo, Japan) and the mean value was calculated [12]. The standard deviation of thickness was computed from the mean value.
Drug content
To check the uniformity of the drug in the strip (1 x 1 mm2), three strips were taken out from each batch. Each strip was then placed in volumetric flask containing 10 ml of distilled water and shaken to extract the drug from the strip. One milliliter of above resulting solution was withdrawn, after suitable dilution with distilled water and analyzed UV-spectrophotometrically at 289 nm using distilled water as blank [13]. The mean and standard deviation of drug content of three randomly selected filmd were calculated. The same procedure was adopted for all the batches and drug content was noted.
Weight variation test
The weight variation test was carried out by weighing three films individually using digital balance (Shimadzu Inc., Japan). The mean weight of insert was noted. [14] The standard deviations of weight variation were computed from the mean value.
Determination of pH of film
For the determination of surface pH of the patch a small area of the film was cut and was allowed to swell by keeping it in distilled water for 1 h in glass tubes. Surface pH was then noted by bringing a combined glass electrode near the surface of the film and allowing it to equilibrate for 1 min. The average of three determinations for each formulation was done [15].
Folding endurance
The folding endurance is expressed as the number of folds (number of times the film is folded at the same place) required to break the specimen or to develop visible cracks. This also gives an indication of brittleness of the film. A film of 2.5 cm × 2.5 cm (6.25 cm2) was subjected to folding endurance by folding the patch at the same place repeatedly several times until a visible crack was observed, and the values were reported [16].
Swelling property of film
Film swelling studies is conducted using simulated saliva solution. A patch of 10 mm size diameter from every batch was a weight on a pre-weight cover slip. It was kept in Petri dish and 10 ml phosphate buffer, pH 6.8 was added. After one hour, the cover slip was removed and measures the weight. The difference in the weight gives the weight increase due to absorption of water and swelling of the patch. The degree of swelling was calculated using formula; [17]

Where: wt is the weight of film at time t, and wo is the weight of film at time zero.
Percentage moisture loss test
Percentage moisture loss test was determined by keeping the films in a desiccator containing anhydrous calcium chloride. After 3 d, the films were taken out, re-weighed and the percentage moisture loss was calculated using the following formula; [18]

Percentage moisture absorption
The percentage moisture absorption test was carried out to check physical stability or integrity of the inserts maintaining high humidity. Three inserts were weighed individually from each batch and placed in desiccators, which maintained high relative humidity (RH) at about 75% RH using an excess amount of salt in solution [18]. After 3 d the inserts were taken out and reweighed. The percentage moisture absorption was calculated using the formula,

In vitro diffusion studies
In vitro drug diffusion studies were carried out to get an idea of permeation of drug through the film. In vitro diffusion study was carried out with the cellophane membrane (0.4µ) by using Franz diffusion cell. The vessel consists of the donor and receptor compartment. The donor compartment was open at the top and was exposed to the atmosphere. The temperature was maintained at 32±0.5 ° C and receptor compartment was provided with sampling port. The diffusion medium used was phosphate buffer (pH 6.8). In vitro drug release study was performed by placing a film of known weight and dimension (1×1 cm2) into a small beaker containing 10 ml of PBS pH 6.8. [19]The beaker was placed on a magnetic stirrer at 30 rpm. At a periodic interval, the samples were taken and the drug content was analyzed at 289 nm against reference standard using PBS pH 6.8 as a blank on a UV–visible spectrophotometer (Shimadzu Inc., Japan).
Stability study
Stability study was performed on optimized formulation (F5), according to ICH guidelines by storing replicates of films (packaged in aluminium foil) in a humidity chamber, with a relative humidity a temperature of 40±0.5 °C 70±5 RH%. At periodic intervals, the samples were taken out at 0, 30, 60, and 90 d and the period for their degradation of the film was checked. Samples were also analyzed for drug content, thickness, weight, surface pH and folding endurance etc [20].
In vitro antibacterial activity
In vitro antibacterial activity was performed on optimized formulations (F5) by placing the films (1 x 1 cm) on agar plates seeded with the oral bacteria ‘Streptococcus aureus’ and ‘E. coli’. After 48 h of incubation at 37 °C, the films were transferred to freshly seeded agar plates and incubated for an additional 48 h [21]. This procedure was repeated until no inhibition of bacterial growth was detected on the agar plate. The growth inhibition zone on the agar plate was measured.
RESULTS AND DISCUSSION
Several methods were described in the methodology for the development and evaluation of film containing Moxifloxacin Hydrochloride as a drug. These formulations were intended to produce the effects in the region of the periodontal pocket. The result and discussion are described under the different heading as follows. In the present study, six formulations were prepared by varying the concentration of polymer and rate controlling membrane (EC). Confirmation of drug test was carried out by FTIR, melting point and by DSC. IR spectrum of the pure moxifloxacin hydrochloride sample recorded by FTIR spectrometer is shown in fig. 1 and their frequencies are compared with the standard as shown in table 2, It was showed that the functional group frequencies of drug were found to be in the reported frequency range thus indicated purity of obtained sample of moxifloxacin hydrochloride.
Table 2: Reported and observed IR frequencies of moxifloxacin hydrochloride
| Functional group | Reported frequency | Observed frequency |
| F | 1400-1000 | 1026.13,1321.24,1396.46 |
| C=O | 1725-1680 | 1710.21 |
| N-H | 3500-3310 | 3471.87 |
| -OH | 3550-3450 | 3529.73 |

Fig. 1: Infrared spectrum of moxifloxacin hydrochloride

Fig. 2: Infrared spectrum of drug+gellan gum physical mixture

Fig. 3: Infrared spectrum of drug+gellan gum+EC+PVP physical mixture
The melting point of moxifloxacin hydrochloride was measured and found to be in the range of 248-252 °C. It was then confirmed with the reported melting point of moxifloxacin hydrochloride. It was also confirmed by differential scanning calorimetry at a scanning rate of 10 °C/min it exhibits a sharp melting endothermic peak at a temperature of 254.96 °C as shown in fig. 4.

Fig. 4: DSC thermogram of moxifloxacin hydrochloride

Fig. 5: DSC thermogram of physical mixture of Moxifloxacin and polymer
The thermogram of Moxifloxacin hydrochloride exhibited an endothermic peak at 254.96 °c while gellan gum and HPMC 15 cps exhibited an endothermic peak between 160-171 °c and 194-203 °c. The peak of moxifloxacin hydrochloride was slightly shifted by 10-15 °c in physical mixture and formulations. The DSC thermogram of physical mixture, as well as formulations, showed identical peaks corresponding to pure drug indicated no chemical interaction between drug and polymers
Physical appearance and Surface texture of developed films along using a different concentration of GG, EC and PVP showed that films were found to be smooth when observed. The formulations prepared with various excipients concentration were observed to be flexible, transperparant, smooth, non-sticky and homogeneous.
Drug loaded formulations (film) were determined for weight uniformity and the results are mentioned in the table 4. The weight of all the equipped batches was found to fairly uniform. Weight of all the prepared films ranged between 5.72±0.24 and 8.42±0.21 mg. By modifying the concentration of polymer GG along with EC and plasticizer could significantly show the dissimilarity in their weight.
The surface pH of the developed formulations was found to be in the range of 6.5-6.9, which is nearly close to the neutral pH, hence it authorized that the films may have less potential to irritate the sublingual mucosa, and therefore, additionally acceptable by the patients.
The thicknesses of prepared formulations were determined with the help of micrometre at three different points (Mitutoyo, Japan). The mean values are shown in the table 3. The drug loaded film did not show any significant change in the thickness of the film. But the insignificant difference was observed among each group, indicated that higher the concentration of the polymer, elevated the values of thickness. It was also observed that there was no any important difference in the thickness among the films, which indicated that the films were uniform.
Table 3: Physicochemical parameters of films containing moxifloxacin hydrochloride
Batch code |
Thickness (mm) (n=3)±SD |
Weight (mg) (n=3)±SD |
Drug content % (n=3)±SD | % moisture loss (n=3)±SD |
% moisture absorption (n=3)±SD |
| F1 | 0.174±0.14 | 5.72±0.24 | 97.86±0.46 | 4.38±0.12 | 6.94±0.23 |
| F2 | 0.169±1.2 | 5.72±0.13 | 98.12±0.14 | 2.18±0.24 | 3.19±0.48 |
| F3 | 0.219±0.14 | 6.14±0.11 | 99.43±0.21 | 4.72±0.16 | 7.86±0.34 |
| F4 | 0.237±1.3 | 6.29±0.16 | 99.26±0.37 | 3.94±0.14 | 5.38±0.22 |
| F5 | 0.274±0.48 | 8.42±0.21 | 99.84±0.12 | 3.75±0.31 | 5.47±0.61 |
| F6 | 0.2.12±0.31 | 7.18±0.42 | 96.54±0.31 | 3.48±0.12 | 3.27±1.32 |
Table 4: Physicochemical parameters of films containing moxifloxacin hydrochloride
| Batch code | Folding endurance | Surface pH | Physical appearance | Surface texture | Swelling index |
| F1 | 197 | 6.5 | Good | +++ | 69.75 |
| F2 | 184 | 6.7 | Good | +++ | 49.87 |
| F3 | 188 | 6.9 | Good | +++- | 71.45 |
| F4 | 164 | 6.4 | Good | ++ | 58.76 |
| F5 | 167 | 6.8 | Best | ++++ | 64.31 |
| F6 | 159 | 6.6 | Best | ++++ | 52.49 |
(+) Indicates Smooth Surface, (-) Rough Surface. Each value is the mean, n=3 determinations
All the films, exhibited good folding endurance (near to 200), which indicates that the films having good flexibility. The percentage moisture loss was determined in triplicate. At dry conditions when the formulation kept moisture loss had been occurred. Formulation F1 showed the maximum amount of moisture loss 4.72±0.16 and formulation F8 had shown less amount of moisture loss 2.18±0.24. It was found that as the thickness of the film increases the moisture loss decreases significantly. The minimum deviations in the above-mentioned formulations indicated that the formulations were maintained their integrity at dry conditions when it was kept in a desiccator and it was viewed by observing the films after percentage moisture loss test.
It is necessary to determine the amount of the drug present in each film so the content uniformity test is generally employed for unit dosage forms. The drug content from the formulations was analyzed at 289 nm by using suitable blank. It was obsvered that the formulations exhibit more than 98% of the dose of a drug which represents very minute amount of the drug was lost, but it within the acceptable limits. The finding results are mentioned in given table 4. The results indicated that the drug was uniformly dispersed.
Swelling study of the formulations was performed according to the procedure mentioned in methodology. The swelling index values of the formulations F1 to F6 is mentioned in table 5. Formulations F3 showed maximum swelling index 71.45 and F2 showed minimum 49.85 swelling index. The maximum and minimum value correspond the polymeric concentrations, as both the polymer as well as rate controlling membrane is belongs to class of cellulose derivatives so it was bound to happen. The formulations that contains highest amount of GG and EC it was observed the high swelling index due to the little bit amount water absorption takes place as compared to the other formulations.
In vitro, drug release studies were carried out in triplicate. For different time interval samples were withdrawn and cumulative percentage drug release was calculated. Cumulative percentage drug release and cumulative percentage drug retained was calculated on the basis of the mean amount of moxifloxacin present in the respective film. Formulation F3 shows a maximum cumulative percentage drug release of 97.34±0.31at the end of 6 h, followed by the formulations F1 (95.96), F2 (92.68). The cumulative percentage drug release for formulations F4 showed 89.96 and F6 88.45 at the end of 8 h. But the formulation F5 could control the release of a drug up to 10h. Therefore, it is probable that drug released from F5, this might be due to the equal concentration of polymer and rate controlling membrane, as well as the addition of PVP, could also hindered the release rate of a drug. Fig. 6 shows plot of cumulative percentage drug release as a function of time for all the six formulations.
Table 5: In vitro drug release study of prepared formulations
| Time (h) | F1 | F2 | F3 | F4 | F5 | F6 |
| 0 | 0 | 0 | 0 | 0 | 0 | 0 |
| 0.5 | 16.64±0.13 | 13.58±0.12 | 14.34±0.64 | 10.45±0.22 | 12.45±0.14 | 11.26±0.21 |
| 1 | 37.48±0.25 | 25.64±0.15 | 29.19±0.14 | 24.52±0.26 | 27.12±0.13 | 25.44±0.43 |
| 2 | 65.78±0.11 | 55.78±1.21 | 46.51±0.34 | 39.14±0.05 | 39.89±0.24 | 39.23±1.2 |
| 4 | 77.12±0216 | 76.15±0.34 | 78.22±0.21 | 54.26±0.34 | 53.23±0.21 | 55.32±0.16 |
| 6 | 95.96±0.14 | 92.68±0.24 | 97.34±0.31 | 71.43±0.13 | 67.12±0.16 | 71.52±0.54 |
| 8 | 89.96±0.12 | 82.36±0.76 | 88.45±0.12 | |||
| 10 | 95.23±1.24 |

Fig. 6: In vitro drug release study of prepared formulations
In vitro antibacterial activity of the optimized formulation (F5) was carried performed following by the procedure mentioned in methodology using S. aureus and E. coli microorganism. The zone of inhibition was found to be the maximum for at first 1 d and decreases as time proceeds. This shows that Moxifloxacin Hydrochloride retains its antibacterial after formulation of the films.
The optimized formulation F5 was evaluated at the particular time interval of 30, 60 and 90 d for all the parameters like Appearance, Weight, Thickness, folding endurance, surface pH and drug content. The findings after stability studies of optimized formulation F5 are given in table 6 and it was found that they did not illustrate any remarkable change in the aforesaid parameters. Drug content was not affected so much but somewhat weight changed this might be due to the environment of the stability chamber. The formulations were also observed for its physical changes, no any kind of changes was observed after three months stability study. It was concluded that the formulations maintains its integratity in terms of drug content, weight, thickness etc and can used in future such a type of delivery of the drug. This confirms the stored film formulation were stable for the period of 90 d.
Fig. 7: In vitro antibacterial study of optimized batch
Table 6: Characterization of film after stability study
| Duration | Film pH | Folding endurance |
Weight of film (mg) |
Thickness of films (mm) |
% Drug content |
| 0 d | 6.8 | 167 | 8.42 | 0.274 | 99.84 |
| 30 d | 6.8 | 164 | 8.45 | 0.268 | 98.69 |
| 60 d | 6.8 | 159 | 8.39 | 0.263 | 98.25 |
| 90 d | 6.7 | 156 | 8.34 | 0.258 | 97.82 |
CONCLUSION
The aforesaid study demonstrates the successful use of dental films and has as a feature in Odontogenic infections. Moxifloxacin Hydrochloride loaded films deliver the drug sustainly. These films consist of Gellan Gum as a polymer, ethyl cellulose can be used as rate controlling polymer, PVP has excellent wetting properties and readily forms films in given concentration and PEG-400 was used as a plasticizer. The compatibility study shows that there is no incompatibility between drug and polymers utilized in the formulations. FTIR and DSC study indicated that there is no interaction between the drug and excipients. The physicochemical study’s results were found to be within the acceptable limits. Total six preliminary batches arranged/prepared to obtained final optimized batch. It was observed that alone GG could not sustained the release of drug concentration but by the addition of rate controlling polymer EC it can controlled the drug release hence their concentrations significantly alters the release profile. In this study best formulation was chosen from each polymer based on release parameters. F5 formulation is considered as the best according to the obtained results and complete drug release profile at the end of 9 h. Stability studies performed showed no significant changes in the films which recommend that the delivery of the film can be used in the management of odontogenic infections.
ACKNOWLEDGEMENT
The authors are thankful to Zydus Cadila Health Care Ltd, Goa, for supplying gift sample of drug, Indoco Remedies Ltd, Goa, for supplying free gift sample of polymers and also thankful to Principal, R C Patel Institute of Pharmaceutical Education and Research Shirpur, for providing the necessary facilities to carry out the research work.
CONFLICT OF INTERESTS
Declare none
REFERENCES
Saxena A, Kitawat S, Gaur K, Singh V. Formulation, development and characterization of floating beads of diltiazem hydrochloride. Int J Drug Delivery Technol 2016;6:1-6.
Frydman WL, Abbaszadeh K. Diagnosis and management of odontogenic oral and facial infections. Oral Health 2014;1. http://www.oralhealthgroup.com
Bresco-Salinas M, Costa-Riu N, Berini-Aytes L, Gay-Escoda C. Antibiotic susceptibility of the bacteria causing odontogenic infections. Med Oral Patol Oral Cir Bucal 2006;11:e70–5.
Poveda Roda R, Bagan JV, Sanchis Bielsa JM, Carbonell Pastor E. Antibiotic use in dental practice: a review. Med Oral Patol Oral Cir Bucal 2007;12:e186–92.
Granizo JJ, Giménez MJ, Bascones A, Aguilar L. Ecological impact of treatment of odontologic infections. Rev Esp Quimioter 2006;19:14–20.
Robert P, Holmes C, Barzani G, Sebastiani FR. Antimicrobial therapy and surgical management of odontogenic infections. A Textbook of Advanced Oral and Maxillofacial Surgery. Vol. 3. Book edited by Mohammad Hosein Kalantar Motamedi, Chapter 1; 2016.
Brook I, Frazier EH, Gher ME. Aerobic and anaerobic microbiology of periapical abscess. Oral Microbiol Immunol 1991;6:123-5.
Gordon JM, Walker CB. Current status of systemic antibiotic usage in destructive periodontal disease. J Periodontal 1993;64:760-71.
Pandit JK. Targeted devices for periodontal disease. In: N K Jain. Ed. Controlled and novel drug delivery. CBS Publishers and distributors, New Delhi, India; 2004. p. 130.
Gorle AP, Gattani SG. Design and evaluation of polymeric ocular drug delivery system. Chem Pharm Bull 2009:57:914-9.
Manoj Kumar, Prabhushankar GL, Satheshbabu PR. Formulation and in vitro evaluation of periodontal films containing metronidazole. Int J PharmTech Res 2010;2:2188-93.
Gorle A, Sadeque M. Formulation and characterization of transdermal film containing ondansetron hydrochloride. J Pharm Sci Innovation 2016;5:125-30.
Mohammed Gulzar Ahmed, Narayana Charyulu, Kanthraj, Harish N, Prabhakar Prabhu. Preparation and evaluation of periodontal strips of gatifloxacin for periodontal diseases. Int J Pharma Biol Sci 2010;1:1-8.
Mastiholimath, Danddagi, Gadad AK, Patil MB, Chandur VK. Formulation and evaluation of ornidazole dental implants for periodontitis. Indian J Pharma Sci 2006;68:71.
Gorle AP, Patil M. Formulation and evaluation of transdermal drug delivery system containing lornoxicam. Res J Pharm Biol Chem Sci 2016;7:21-48.
Nair SC, Anoop KR. Design and in vitro evaluation of controlled release satranidazole subgingival films for periodontitis therapy. Int J Pharm Sci Rev Res 2014;24:8-14.
Vineetha VC, Mathews MM. Development and evaluation ff dental films containing an antibacterial agent for the treatment of periodontitis. Int J Pharm Pharm Sci 2014;7:52-9.
Gorle AP, Gattani SG. Development and evaluation of ocular drug delivery system. Pharm Dev Technol 2010;15:46-52.
Katiyar A, Prajapati SK, Ali A, Vishwkarma SK. Formulation and evaluation of dental film for periodontitis. Int J Pharm 2012;3:143-8.
Sajid Ali, Javed Ali, Alka Ahuja, Sarfaraz Alam. Formulation and characterization of dental film containing ofloxacin. J Appl Pharm Sci 2012;2:114-9.
Hebbar S, Nayak S, Nayak Shwetha, Manja N, Shabaraya AR. Ormulation and evaluation of levofloxacin dental strips for periodontitis diseases. Am J PharmTech Res 2013;3:948-55.
How to cite this article
Gorle AP, Mahale HV, Patil CS. Effective management of odontogenic infections through controlled fashion by a polymeric device containing moxifloxacin. Int J Curr Pharm Res 2017;9(5):100-106.